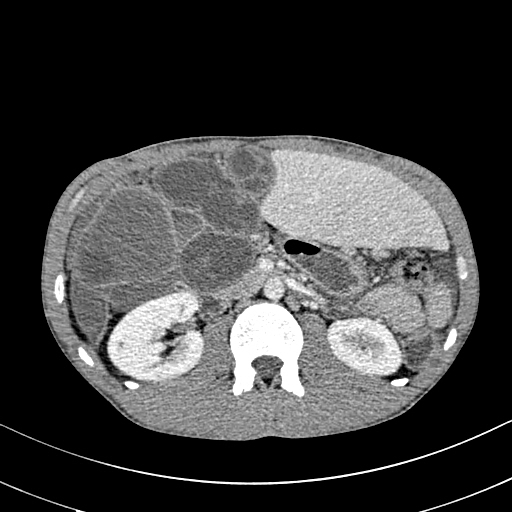
Figure/Patient 3An 8 year-old girl with prior surgical excision of a right latero-cervical lymphangioma presenting with a new-onset tumefaction within the same region. MRI scans show a 9-10 cm subcutaneous multilocular lesion, extending between two virtual planes crossing the retro-molar trigone and the thyroid respectively, with deep invasion of parapharyngeal spaces cranially and the space between the submandibular gland and the vascular peduncle of the neck caudally. The lesion appears hyper-intense on T2 weighted scans with (A-B) and without (C-D) fat suppression, hypo-intense on T1 weighted scans with (E) and without (F) fat suppression and hyper-intense on DWI scans with high B values (G). Diagnosis of loco-regional recurrence of cystic lymphangioma is done.

Background ymphangiomas (Lms) or, as recently preferred (according to ISSVA classification for vascular anomalies 2018), "lymphatic malformations" consist of lymphatic channels anastomosis and cystic spaces, as a result of abnormal connections between the lymphatic and venous systems or abnormal development or location of lymphatic vessels. Their incidence is 1/12000 births, accounting for 6% of all benign lesions of infancy and childhood. Cervico-facial lesions represent 75% of the cases and 80-90% become symptomatic within the first 2 years of life (both sexes equally affected) because of their progressive enlargement with growth. Many of them are congenital and often associated with other vascular or chromosomal abnormalities (e.g. Turner syndrome), without a clear familial tendency; however, they may arise or increase in size due to trauma, inflammation or lymphatic obstruction. Spontaneous regression within 18-24 months is documented in 1.6-16% of cases. Classification into macro-cystic, micro-cystic and mixed is based upon the diameter of the cysts. Presentation varies from asymptomatic, soft, not compressible, transilluminant neck tumefaction to dysphagia, malocclusion, sleep disordered breathing, respiratory distress and recurrent infections [1]. Since they are not encapsulated, they show infiltrative growth and often are not dissociable from airway, nerves and blood vessels [2].
Histology is similar to hamartomas, although some state a lymphangiectasic or neoplastic nature, without any malignant potentiality [3]. Ultrasonography documents mono-or multiloculate fluid-superfluid lesions with a substantial lack of flow with Doppler mode (figure/patient 1-2). Computer Tomography (CT) describes low attenuation masses with occasional fluid level and minimum septal and peripheral enhancement. Magnetic resonance imaging (MRI) detects iso-or hyposignal on T1-weighted sequences and hyper-signal on T2-weighted sequences, a halo of enhancement around the septa of macro-cystic lesions and peri lesional lymphoedema (figure/patient 2-3) [4].
While small and asymptomatic lesions might benefit from purely conservative management (e.g. compression, analgesia), larger and symptomatic (e.g. dysphagia, dyspnoea) malformations would require non-conservative treatment; this implies a multidisciplinary approach (surgical, radiological, physician's) which varies according to each patient's characteristics and lesions, considering the lack of univocal indications for treatment as well as all those issues related to the young age of the patient (psychological or parental concern). Traditional surgical treatment has been considered for many years the gold standard for lymphatic malformations and is still considered the most definitive solution; however, as lymphangiomas are infiltrative, a complete eradication is often impossible [5]. This explains the relatively high percentage of recurrences (up to 27%) and intraoperative risks, with a mortality rate of 2-6%. At the present, surgery is indicated for lesions larger than 3 cm (sometimes for debulking, followed by sclerotherapy), with progressive growth, bone erosion, dyspnoea or dysphagia [6]. It is also advocated for the resection of remaining fibrotic tissue after sclerotherapy or as a first-line therapy for lesions outside the cervico-facial region, associated with few intraoperative risks or aesthetic sequelae [7]. Minor complications include lymphorrhea, keloids, dehiscences, fistulas, and the need of a prolonged postoperative drainage from the wound, with an associated risk of infection [8].
The aim of the study was to review and discuss the non-surgical strategies for the management of cervical lymphangiomas, with particular attention to the sclerosing agents.
All relevant articles including "cervical lymphangiomas" or/and "sclerotherapy" were searched on PubMed, Cochrane and Embase platforms. Inclusion criteria were: (1) studies published mostly within the last fifteen years, (2) studies including paediatric population, (3) studies reporting advantages, success rate, recurrence rate, complications and dose for each and every sclerosing agent, (4) studies written in English. In addition, instructions for the procedure of ultrasound or CT-guided sclerotherapy and other alternative treatments were considered.
As many as 47 articles dealing with sclerotherapy of cervical lymphangiomas in children were collected. Beside short information about the first therapeutical approaches, laser therapy, radiofrequency ablation and oral medications (e.g. Sirolimus) including the newest target-therapy, a much larger knowledge was obtained about sclerotherapy's rationale, steps and agents, from the most employed (OK-432, bleomycin/ pingyangmycin, doxycycline, sodium tetradecylsulphate) to potential alternatives (such as ethanol) or occasionally-used substances (e.g., acetic acid, Ethibloc, Tissucol, Polidocanol).
Historically, the first non-surgical treatments for cervical lymphangiomas were with simple direct drainage, aspiration and radiation. A combined radiochemotherapeutic approach was performed in selected cases of hemolymphatic malformations [1].
Laser therapy is an alternative to surgery for small and superficial (cutaneous or oral) lymphangiomas or for debulking of invasive, large and non-excisable lymphangiomas. Traditional techniques consist of the resection and removal by photocoagulation with argon, carbon dioxide, Nd:Yag, KTP and diode lasers. Pain, oedema and swelling are associated with complete healing at 6-8 weeks, although a scar may persist for many years. Ten to 33% of cases are complicated by intraoperative bleeding or nerve injury. Namour and coll suggested a peculiar therapeutic method for debulking of invasive and extensive lesions within oral soft tissues, preventing the patients from mutilation. A CO2 laser machine with output power of 2W in defocus and in non-contact mode for at least 3 min is used, with a distance between the laser handpiece and the tissular impact point around 6 cm, the delivered focal point at 0.3 mm, the effective spot diameter range at tissue at about 2 cm (power density = 0.63W/cm2) and the estimated energy density range at 114.65-191 J/cm2. This protocol does not cause disintegration/vaporisation but only overheating, with subsequent fibrous healing. Out of seventeen patients, only three (18%) experienced recurrence and no major complication (embolism, infection or mutilation) occurred. Other minor treatments include cryotherapy, diathermy and electrocautery [9].
Another example of local treatment is offered by radio-frequency ablation (RFA) or hypothermic ablation, destroying lesions at lower temperatures (40-70°) with subsequent lower damages within surrounding tissues. Micro-cystic lymphangiomas in mouth, throat, pharynx, retro-pharynx and tongue may benefit from RFA, which also helps to stop accidental or intra-operative bleedings [10].
Sclerotherapy is nowadays largely employed in case of macro-cystic or mixed lymphangiomas, where the size of the cysts allows them to be punctured and a wider distribution of the agent is achieved. However, OK-432, bleomycin and above all doxycycline have recently proved effective also with micro-cystic variety [2]. The rationale comes from the observation that lymphangiomas can reduce their size or regress after a spontaneous infection, probably due to the destruction of the epithelium, reduction of lymph production and collapse of the cyst: thus, the idea of adopting sclerosing agents to mimic such an effect. Puncture of the dominant cyst (or more, in case they are noncommunicating) with a fine needle (20 G or more) is followed by aspiration (in order to enhance the SA effect) and injection, in one or more times, of the sclerosing agent, using the same amount as the aspirated fluid (if impossible, half of the lesion's volume). It can be repeated in case of partial response or whenever more administrations are chosen, each session being separated by weeks up to a month. General or loco-regional anaesthesia is preferred in children or uncooperative patients and in adults or small cystic malformations, respectively; the patient's position is changed many times to favour a uniform distribution of the agent and the treatment lasts up to two hours. A postoperative compressive bandage is advised in order to increment the time of contact between the solution and the cyst's wall and to prevent seroma formation, bleeding or effusion of the SA. The procedure can be performed under ultrasound or CT: the first is cheaper, more available, does not employ ionising radiations (thus being advisable in children and young adults), defines better the different components within the lesion, grants different cranio-caudal angles and reduces the risk of accidental puncture of large blood vessels; however, it is operator-dependent and offers a narrow field of view, with the risk of missing some important findings, especially at the post-procedure check. CT instead is easier to perform and provides a more panoramic view but implies radiation and the needle path to lie on the axial plane with its full length [1]; a detailed example of this procedure is offered in figure (patient) 4, whereas figures (patients) 5 and 6 show examples of successful outcomes comparing lymphangiomas before and after sclerotherapy. Fluoroscopic guidance is also reported, especially in case of the most superficial lesions, with the possibility to inject contrast medium into the lesion in order to highlight communications between the intra-lesional spaces and establish the amount of SA to be used [4]. Complications include intraoperative bleeding (due to their dysplastic nature), accidental injuries to nerves, vessels, organs and other tissues (due to extravasation), peri-lesional fibrosis and aesthetic sequelae (due to necrosis followed by second-intention reparation), dosedependent cardio-pulmonary toxicity (especially with bleomycin) and acute respiratory insufficiency (with large lymphangiomas undergoing inflammation, necrosis and quick volumetric expansion); the latter could be managed with dexamethasone or, preferably, avoided by splitting the treatment in more sessions [7]. An example of follow-up program would consist of a clinical examination after one to three weeks, ultrasonography after six to twelve weeks and then (depending on the results of ultrasound) MRI, unless evidence of early recurrence or any other complication occurs [8]. A review by Adams et al didn't prove the superiority of sclerotherapy over surgery but showed it was the treatment of choice in most major paediatric vascular anomaly centres: surgery was reserved for refractory cases, with sclerosing agents not improving either clinics or aesthetics, micro cystic lesions or those associated with life-threatening airway obstruction. Nowadays there are no worldwide-accepted guidelines and patient selection seems to guide the choice. In addition, neither surgery nor sclerotherapy can guarantee complete healing with just one session: it is actually advisable to perform multiple treatments or combine them [1].
When dealing with sclerotherapy, the first substances to be employed (with poor results) were boiling water, quinine, urethane, iodine tincture, nitromin, sodium morrhuate 5% and acetic acid 40 to 50%, the last two with little more reference in literature [1]: sodium morrhuate is currently employed for orbital lymphangiomas; acid acetic causes an area of coagulative necrosis much wider than ethanol (with pain and tingling sensation) but with a faster and more complete regression [11]. Many others sclerosing agents (SA) were used by the years, but no guidelines are currently available due to the infrequency of the disease and the limited studies; therefore, the decision is based on Centres and operators according to their experience and the availability and side-effects of the agents [12].
OK-432 (Picibanil; table 1) was first used by Ogita in 1987 [13]. It comes from the lyophilisation of a mixture of Streptococcus pyogenes and G-Penicillin. It favours the production of IL-1, IL-2, IL-6, INF-Æ?" and TNF, the activation of neutrophils, macrophages, NK and T lymphocytes, the apoptosis of the epithelium and increases the permeability of the endothelium, accelerating the lymphatic fluid drainage. Compared to others SA, OK-432 is associated with a lower risk of extravasation and subsequent peri-lesional fibrosis, systemic toxicity or/and aesthetic sequelae [14]. In addition, according to both Efe and Hazim (2016), the lesion is still feasible for surgery even after sclerotherapy failure [15,16]. Luzzato et al (2000) confirmed its usefulness for residual and recurrent lesions, as well as the low invasivity and scarring [17]. Sichel et al (2004) agreed with the lack of a significant peri-lesional fibrosis [18]. The percentage of success is 50-92% (remaining high even with repeated injections), with 43% of complete and 29,3% of partial remissions [19], whereas the frequency of the recurrences is around 11% [15] and the complications are rare and mostly local (pain, heat, induration, erythema, oedema, swelling, aesthetic sequelae, swallowing difficulty and odynophagia, infections) with sporadic fever, sepsis and shock, especially in patients with allergy for G penicillin [1]. Yoo et al (2009) stressed the safety of OK-432, reporting minor complications only and stating a high long-term efficacy [20]. Rebuffini et al (2012) also reported anaemia and a transitory increase of platelets' concentration [21]. The low systemic toxicity allows OK-432 to be used also with micro-cystic (where the percentage of success reaches nearly 50%) or intraparenchymal components, where the risk of tissue absorption is the most [22]. Ruiz et al (2004) confirmed its feasibility for micro-cystic lesions, as well as those associated with a risk of airway obstruction [23]. Ogita recommends 0,1 mg/10 cc with a maximum of 20 mL of solution or 0,2 mg of substance [24]. Despite all its advantages and proven effectiveness, however, OK-432 is less and less employed in the UK.
Bleomycin sulphate (table 2) is an antibiotic with antitumour action, inhibiting DNA synthesis. Tanigawa et al were the first to employ it as a sclerosing agent, reporting a lower recurrence rate than surgery and stating the possibility to use it in case of surgery failure [25]. Sung et al also used it for debulking of unresectable lesions [26]. It shows good responsivity (88%), a discrete frequency of complete remissions (36-63%) and a low recurrence rate (15%), as sclerosing agent [27]. Zulfiqar et al (1999) confirmed it safety and effectiveness, especially when dealing with macro-cystic lesions [28]; a decade later, Sanldas et al (2011) confirmed a higher success when treating unilocular malformations [29]. Analogous outcomes, along with similar success rates, were obtained by Kurmar (2012) [30], Jain (2013) [31], Porwal (2018) [32] and Hashmi (2020) [33]. Orford et al (1995), obtained minimal surgical scars and declared a low risk of potential injury of nerves and/or blood vessels. Local signs of inflammation (restricted movement of the neck, pain, swelling, induration, stridor, difficulty in breathing or swallowing, intra-luminal bleed, infections) subside spontaneously within few days. Systemic effects range from mild (vomiting, diarrhoea. flu, local hyperpigmentation, hyperkeratosis and thickening of the skin) to anaphylaxis [34]. Mathur et al (2005) declared no major complication or mortality [35]; the same conclusion was drawn by Rozman (2010) [22]. Sporadic cases of pulmonary fibrosis actually occur only when high doses are employed (total administration of 400 U or single administration of 30 mg/mm 2 ), as during systemic chemotherapy or with renal clearance under 25-35 mL/min. Follow-up to monitor for pulmonary fibrosis is left to exercise tolerance and patients are also advised to avoid live vaccine for 3 months. The suggested dose is between 0,5 and 1 mg/kg with a maximum of 5 mg/kg [35].
Pingyangmycin or bleomycin A5 (table 4) is similar to common bleomycin (A2) but it is cheaper and determines less peri-lesional fibrosis and complications, with possible hair loss, gastrointestinal reactions, fever, rash. The recommended dose is 1 mL/cm 2 and must be lower than 8 mg per single injection and 40 mg in total. Jia et al. (2014) treated orbital and peri-orbital lymphatic malformations with PYM, with a mean volume decrease of 84% after a median number of 2 injections, and no recurrences at 8 months were observed [12]. Gao (2002) employed it also with oral, maxillofacial and cervical lesions, considering it as a potential primary therapy [14]. Doxycycline (table 3) is a bacteriostatic antibiotic, which inhibits angiogenesis through the blockage of the production of metalloproteinases and vascular endothelial growth factor (VEGF) [10]. It is inexpensive, widely available and it has minimal side effects, including dental discolouration in children, allergic reactions [2], haemolytic anaemia, hypoglycaemia, neurological complications and rare cases of methaemoglobinaemia [36]. Pain, swelling, haemorrhage and cellulitis may occur, as well as scarring, skin excoriation and Horner's syndrome [2]. Complete or near complete response was achieved from the very beginning of its use, as reported from the experience of Cordes (2007) [37] and Nehra (2008) [38]. Later, Jeffrey Cheng (2015) performed sclerotherapy with doxycycline on a larger cohort of subjects, reporting an efficacy of 84.2%, and insufficient responses or recurrences in 33% [2]. The recommended dose varies between 20 and 150 mg at a concentration of 10 to 20 mg/mL [36]. Despite many Authors, such as Cahill (2011) [39] and Farnoosh (2015) [36], state its primary role for the treatment of large macro-cystic malformations, some others like Burrows (2008) declare an even higher efficacy than OK-432 in case of microcystic lesions [11]. Shields (2009) agreed with the former and employed it also in cases of post-surgical recurrences [40]. Shergill (2012) put together the theories from the previous authors claiming that doxycycline could be used for nearly all types (macrocystic, micro-cystic or mixed) of lymphangiomas [41].
Despite the few quotations, sodium tetradactylsulphate or sotradecol 3% (table 4) is used in many paediatric centres in the UK as second like after doxycycline. It has shown to determine an average response of 80-90% (complete in 40%) and complication rate of 17% only, including swelling, oedema, mild allergic reaction, chronic facial pain, infections, cutaneous necrosis and nerve injury. Dose varies between 3 to 6 mL and its main indication remains orbital LM [25]. Farnoosh (2015) achieved similar results, with an even better outcome if combined with doxycycline [36].
Alcohol 98% (table 4), used for many arteriovenous malformations, causes rapid cellular dehydration and protoplasm precipitation. On one hand, it shows good therapeutic response (from 64 to 96%), large availability and low cost. On the other hand, it can determine unexpected damage within the surrounding tissues and, at high doses, severe systemic effects such as hypotension, respiratory depression, arrhythmias, seizures, hypoglycaemia and exitus. For this reason, low doses are employed (0,5-1 mL/kg), mostly associated with injuries of skin, mucosae and peripheral nerves (7,5-27,95%) or thrombotic phenomena. Recurrence rate is around 30% [6]. Impellizzeri et al. (2010) reported their experience with CT-guided instillation of 5-15 mL of alcoholic solution with complete disappearance of the lesion in 7 patients, with only one needing a second injection. Only one patient experienced self-limiting erythema and tenderness and no recurrence was observed at 2 years [1]. Puig et al. affirmed that the use of ethanol for lymphatic malformations could cause the extravasation as a major risk. To avoid it, he proposed a double-needle procedure to limit the total volume of ethanol injected in order to reduce intra-lesional pressure and thus extravasation [42]. Ethanolamine oleate is obtained from a combination of an organic base with oleic acid and shows alcohol-like effect, although it has lower toxicity [12].
Although few experiences about the use of acetic acid at 30-50% (table 4) demonstrate a more rapid effect compared with the other SA and the frequent need for a single treatment session only, the extravasation into the nearby tissues represents a serious issue. As an example by Won et al, a patient with a cervico-mediastinal lymphangiomas experienced infiltration in the lung parenchyma surrounding the lesion [43].
Alcoholic solution of Zein (Ethibloc, table 4) contains Zein (a prolammine), diatrizoate sodium (radioopaque marker), poppyseed oil and 96% ethanol. It is biodegradable, effective and safe, but the risk of scars, salivary fistulas, infections and the poor aesthetic results (30 days of trans-cutaneous elimination) have limited its use. The recommended dose is between 1 and 7,5 mL. M. A. Emran et al. reported satisfactory to excellent results in 84% of macro-cystic/mixed and in 77% of micro-cystic lesions and considered Ethibloc an effective alternative to surgery for macro-cystic lymphangiomas or post-surgical recurrences. Failure and subsequent recurrence rate seems around 23% [44].
Fibrin glue (Tissucol, table 4) is an expensive haemostatic agent making the cysts collapse, the dose being 10 to 15% of the suctioned volume; Castañon et al obtained complete remission of 8 of 9 monocystic neck lymphangiomas [45]. Polidocanol (table 4), a local anaesthetic, is administered at the dose of 1 mL for each cm of lesion, does not need further anaesthesia and causes erythema with induration of the skin only; Jain et al achieved a volume reduction of 96% to 100% in 3 patients [46].
To the knowledge, some substances are administered orally in addition to local treatments and overseen by a physician in normal circumstances. Sirolimus or rapamycin is a mTOR-PI3K pathway inhibitor increasingly employed when surgery fails or is not feasible. It has been used for orbital lymphatic malformations and (later) conjunctival or superficial periocular lesions [12,47]. Other systemic treatments include Cyclophosphamide (alkylating antineoplastic agent), interferon, steroids (promoting inflammation and cicatrisation respectively), isotretinoin, Bevacizumab, Thalidomide (anti-angiogenic), Alpelisib and TIE2 (targeted therapy against PIK3CA and tunica intima endothelial kinase 2), propranolol and sildenafil (relaxing smooth muscle thus causing cystic decompression and opening of secondary lymphatic spaces). The last one, a phosphodiesterase type 5 inhibitor used for erectile dysfunction and pulmonary hypertension, proved effective in reducing the number and severity of bleeding episodes, especially with macro-cystic and mixed lesions [12]. Newest targettherapies, appearing more effective with macro-cystic lesions, include PI3K inhibitors (LY294002, BYL719, wortmannin), AKT inhibitors (ARQ092, MK-2206), MAPK inhibitors, (U0126), multiple kinase inhibitors (sorafenib, trametinib), VEGF-A inhibitors (bevacizumab), BMP and Wnt modulators (dorsomorphin, LDN-193189 and calyculin A), JAK inhibitors (ruxolitinib), calcium channel blockers (amlodipine), KATP activators (minoxidil), zoledronic acid, interferon a 2b, prednisolone, sunitinib. However, large-scale studies are required in order to confirm efficacy and potential side-effects for each substance [10].
A recent review by Liu et al. (2021) confirms how, although surgery remains the first-line strategy for lymphangiomas (especially large lesions for possible complete removal), risk of scars, incomplete resection/recurrences and injury to blood vessels or cranial nerves (especially the submandibular branch of the facial nerve) is high. Thus, despite above-mentioned side effects like soft-tissue oedema and skin necrosis as well as variable recurrence rates, sclerotherapy may often represent the elective treatment; moreover, microcystic lesions appear more and more susceptible to SA like OK-432. However, since "single treatments" often achieve insufficient results, ongoing strategies tend to administer multiple therapies. For example, surgery may obtain debulking of large lesions, with remaining tissue being treated with sclerotherapy (e.g. bleomycin) and systemic drugs administered to alleviate the symptoms of pain and bleeding. Analogous strategies might be employed with superficial micro-cystic mucosal lesions, where RFA or laser-therapy plays the main role. Moreover, oral medications themselves may be used prior to surgery and/or sclerotherapy. However, further studies are necessary in order to promote univocal guidelines; thus, to date, as already stated by Liu et al., "individual therapies" (also including target-therapy) represent the most appropriate strategy in the treatment of lymphangiomas, with no exception for cervical lesions [10].
V.
Treatment of cervical lymphangiomas represents a rare but challenging issue. Despite the wide range of treatments discussed, cervical lymphangiomas remains a relatively infrequent finding. Thus, a limited number of studies is reported in literature and small cohorts of patients are considered, with subsequent difficulties in performing a reliable metaanalysis about the efficacy of any single treatment.
Despite the lack of worldwide-accepted guidelines, our research highlights the role of sclerotherapy as the first-line non-surgical strategy because of the lower rates of aesthetic sequelae, recurrence, complications (e.g. injury to blood vessels or cranial nerves) and mortality and the better course, so that it might represent a valid or equivalent alternative to surgical therapy. Moreover, the two treatments can be used in combination (e.g. when remaining lymphangiomatous or fibrous tissue is present) or sclerotherapy can prove more efficient (e.g. micro-cystic lesions when using OK-432). Sclerosing agents should usually be employed with macro-cystic lesions, and no substantial difference is reported in terms of efficacy from a SA to another, all of them ranging from about 60 to 90% in different studies. Although no longer used in several countries (including the UK), OK-432 would be optimal for its minimal extravasation (and thus perilesional fibrosis and aesthetic sequelae), the lowest rate of both local and systemic complications and recurrences (around 10%) and, eventually, the feasibility with either micro-cystic lesions. Bleomycin can represent a valid option as long as low doses are administered, due to the well-known risk of pulmonary fibrosis; the issue is partially solved when employing pingyangmycin which is still, however, indicated mostly for peri-ocular lesions. Doxycycline is more available, cheap and apparently even more efficient than OK-432 in cases of micro-cystic lymphangiomas; as an alternative, we suggest tetradactyl-sulphate. Despite its wide availability and low cost, the higher risks of neurovascular/visceral injuries (about 10 to 30%), systemic side effects and recurrences (around 30%) make ethanol a definitely second-line treatment.
However, several considerations must be made. Firstly, multicentric prospective studies are necessary in order to better evaluate this technique and define the best sclerosing agent to be used. Secondly, as already mentioned, ongoing strategies tend to combine the above-mentioned treatments (including oral medications and the newest "target-therapies") according to each patient's characteristics and lesions (as well as psychological aspects), giving rise to a multi-faceted approach.
The authors declare that no funds, grants, or other support were received during the preparation of this manuscript.

| Advantages | Success rate | Recurrence rate Complications | Dose | ||||||
| Ogita S. et al | Low | toxicity, | 89% | (total: | 9 | 11% | Local | As much as aspired | |
| (1987) [13] | immuno- | patients) | inflammation, | by mixing each 0.1 | |||||
| stimulating effect | fever | mg with 10 cc | |||||||
| distilled water, not | |||||||||
| exceeding 0.2 mg on | |||||||||
| total; next injection at | |||||||||
| 3-4 week | |||||||||
| Luzzatto G. et | effective | for | Excellent results in | 9.1% | Fever, signs of | 0.1-0.2 mg/dose (one | |||
| al (2000) [17] | primitive, residual | macrocystic, good | local | to 16, average 3) | |||||
| and | recurrent | and poor in 25% | inflammation, | ||||||
| lesions, | low | and 75% of mixed | cervical swelling | ||||||
| invasivity | and | type (total: 11 and | needing | a | |||||
| scarring | patients respectively | feeding tube | |||||||
| Advantages | Success rate | Recurrence Rate | Complications | Dose | |
| Tanigawa et al | Less recurrences | excellent results in | none | Swelling, fever, | 0.3 to 0.5 ml, |
| (1987) [25] | when compared | 53%, good results in | vomiting, | once every 4 to | |
| with surgery, | 47% (total: 15 | diarrhoea, local | 6 weeks, | ||
| feasible after | patients) | infection, | microsphere in- | ||
| surgery failure | dyspnoea | oil emulsion | |||
| Sung et al | feasible with | complete or nearly | None within | local swelling and | 1 mg/mL, from 3 |
| (1995) [26] | unresectable | complete shrinkage | responding | inflammation, | to 7 sessions |
| lesions | 40%, marked | lesions | pneumonia of | ||
| (debulking) | reduction in size in | uncertain origin | |||
| 30%, partial or | |||||
| minimal reduction in | |||||
| 30% (total: 10 | |||||
| patients) | |||||
| Orford et al | low risk of | excellent results in | 9% | fever, vomiting, | 0.3 to 0.6 |
| (1995) [34] | neurovascular | 45%, good in 36%, | cellulitis, skin | mg/kg | |
| damage, no | no response in 18% | discoloration | |||
| surgical scar | (total: 11 patients) | ||||
| Zulfiqar et al | Safe and | excellent results in | None in short- | none | 0.5 mg/kg from |
| (1999) [28] | effective, | 36%, good in 45%, | term | 1 to 4 sessions | |
| especially in | no response in 18% | ||||
| macrocystic | (total: 11 patients) | ||||
| lesions | |||||
| Mathur et al | no major | complete or near | 30% (70% | local swelling and | 1 mg/kg with a |
| (2005) [35] | complications, no | complete response | residual | inflammation | maximum of 6 |
| mortality | in 30%, good | disease) | mg/kg, every 2 | ||
| response in 70% | weeks, in a | ||||
| (total: 10 patients) | solution of 1 | ||||
| mg/ml in large | |||||
| lesions and 2 | |||||
| mg/ml in smaller | |||||
| lesions. | |||||
| Rozman et at | Safe and | Complete resolution | 8% | Swelling, stridor, | 0.5 mg/kg with a |
| (2010) [22] | effective, no | in 63%, good | difficulty in | maximum of 5 | |
| major | response in 21% | breathing or | mg/kg, from one | ||
| complication | and poor response | swallowing, pain, | to six sessions | ||
| when using | in 16% (total: 22 | tenderness, | |||
| normal doses | patients) | erythema | |||
| Sandlas et al | Safe and effective | significant response | None within | fever, swelling, skin | 0.6 to 0.8 mg/kg |
| (2011) [29] | with unilocular | in 53.33%, good | responding | discoloration | |
| lymphatic | response in 33.33% | lesions | |||
| malformations | poor response in | ||||
| 13.33% (total: 15 | |||||
| patients) | |||||
| Kumar et al | Safe and effective excellent response | None within | fever, transient | 0.5 mg/kg body | |
| (2012) [30] | in 20%, good in | responding | increase in size of | weight, no more | |
| 74.29%, poor in | lesions | swelling, local | than 10 units at | ||
| 5.71% (total: 35 | infection, | a time | |||
| patients) | intraluminal bleed, | ||||
| skin discoloration | |||||
| Advantages | Success rate | Recurrence Rate | Complications | Dose | |
| Cordes et al | readily available, | Resolved or | None within | Swelling, | 10 mg/mL |
| (2007) [37] | inexpensive | marked reduction | responding | haemorrhage | |
| in all patients | lesions | into the cystic cavity | |||
| (total: 12 patients) | |||||
| Nehra et al | readily available, | Complete | 18% | None | 10-mg/mL up to |
| (2008) [38] | inexpensive | response in | a maximum of | ||
| macrocystic | 200 mg | ||||
| lesions, partial | |||||
| response in mixed | |||||
| lesions | |||||
| (total: 11 patients) | |||||
| Burrows et | Effective, safe, few | Excellent | None within | pain and | 10 mg/mg, with a |
| al (2008) | complications | response in | responding | swelling, skin | maximum dose |
| [11] | macrocystic | lesions | blisters, hair loss, | of 1000 mg | |
| (90%), good in | Horner's syndrome | or 20 mg/kg, | |||
| combined (80%) | from 1 to 6 | ||||
| and in microcystic | administrations | ||||
| (60%) lesions | |||||
| (total: 41 patients) | |||||
| Shiels et al | Feasible for primary | Excellent | 13% | Cellulitis, | 20 mg/mL, one |
| (2009) [40] | lesions (even | response in 90% | haemorrhage into | to four sessions | |
| microcystic) | (total: 17 patients) | cysts | |||
| or post-surgical | |||||
| recurrences | |||||
| Cahill et al | Feasible for large | Excellent | None within | emolytic anaemia in | 10 mg/mL with a |
| (2011) [39] | macrocystic head | response in 65%, | responding | 2 infants, | dose range of 50 |
| and neck lymphatic | good in 23%, | lesions | hypoglycaemic and | to 500 mg | |
| malformations | poor in 12% (total: | metabolic acidosis, | |||
| 17 patients) | transient | ||||
| hypotension, skin | |||||
| excoriation, delayed | |||||
| neural | |||||
| complications, | |||||
| Horner's syndrome, | |||||
| transient left lip | |||||
| weakness, right | |||||
| facial nerve palsy | |||||
| and left | |||||
| hemidiaphragm | |||||
| paralysis |
| Advantages | Success rate | Recurrence rate | Complications | Dose | |||||
| Pingyangmicin | feasible for | marked | none within | swelling of the | |||||
| (Jia et al, 2014) | orbital or | improvement in | responding | conjunctiva, | 1 mL/cm 2 , be | ||||
| [12] | periorbital | 76%, moderate | patients | localized | lower than 8 mg | ||||
| malformations | in 18% (total: 33 | subcutaneous | per | single | |||||
| patients) | atrophy | injection and 40 | |||||||
| mg in total | |||||||||
| Pingyangmicin | could be the | curative in | none within | mild and local | 5 mg to 70 mg | ||||
| (Gao et al, 2002) | primary therapy | 100% of cystic, | responding | and 5 to 58 | |||||
| [14] | for oral, | 46.36% of | patients | times, 1 time per | |||||
| maxillofacial and | capillary, | 2-4 weeks | |||||||
| cervical lesions | 16.16% of | ||||||||
| cavernous and | |||||||||
| 19.05% of mixed | |||||||||
| capillary and | |||||||||
| cavernous | |||||||||
| lesions | |||||||||
| (total: 195 | |||||||||
| patients) | |||||||||
| Alcohol | 98% | large availability | 100% (total: 8 | none at 2 years | erythema | and | 5-15 | mL | of |
| (Impellizzeri et | and low cost | patients) | tenderness | (if | solution, | each | |||
| al, 2010) [1] | high doses are | but one needing | |||||||
| employed: | one session only | ||||||||
| hypotension, | |||||||||
| respiratory | |||||||||
| depression, | |||||||||
| arrhythmias, | |||||||||
| seizures, | |||||||||
| hypoglycaemia, | |||||||||
| exitus) | |||||||||
The authors have no relevant financial or nonfinancial interests to disclose.
All authors contributed to the study conception and design, read and approved the final manuscript.
All procedures performed in studies involving human participants were in accordance with the ethical standards of the institutional and/or national research committee and with the 1964 Helsinki declaration and its later amendments or comparable ethical standards.
Informed consent was obtained from all individual participants included in the study.
Consent for publication was obtained for every individual person's data included in the study.
The authors affirm that human research participants provided informed consent for publication of the images.
Sclerotherapy with bleomycin does not adversely affect facial nerve function in children with cervicofacial cystic lymphatic malformation. J Pediatr Surg 2010. 45 (8) p. .
Efficacy of intralesional bleomycin injection sclerotherapy in macrocystic lymphangioma in paediatric patients. J Ayub Med Coll Abbottabad 2020. 32 (1) p. .
Sclerosing treatment of lymphangiomas with OK-432. Arch Dis Child 2000. 82 (4) p. .
Picibanil (OK-432) in the treatment of head and neck lymphangiomas in children. Dent Res J. (Isfahan) 2012. 9 (2) p. .
OK-432 therapy for lymphangioma in children. J Pediatr. (Rio J) 2004. 80 (2) p. .
Bleomycin: A worthy alternative. Indian J Plast Surg 2011. 44 (1) p. .
Treatment guidelines of lymphatic malformations of the head and neck. Oral Oncol 2011. 47 (12) p. .
Cross sectional study comparing different therapeutic modalities for cystic lymphangiomas in children. Clinics (Sao Paulo) 2014. 69 (8) p. .
Doxycycline sclerotherapy in children with head and neck lymphatic malformations. J Pediatr Surg 2015. 50 (12) p. .
OK-432 sclerotherapy in head and neck lymphangiomas: Long-term follow-up result. Otolaryngol Head Neck Surg 2009. 140 (1) p. .
Bleomycin Therapy for Cystic Hygroma. J Pediatr Surg 1995. 30 (9) p. .
OK-432 Therapy for Cervical Lymphangioma. Laryngoscope 2004. 114 (10) p. .
The Treatment of Neck Lymphangioma with Intralesional injection of Bleomycin. Med J Malaysia 1999. 54 (4) p. .
Intralesional Injection of OK-432 in Cystic Hygroma. Med J Malaysia 2016. 71 (6) p. .
Response to OK-432 sclerotherapy in the treatment of cervical lymphangioma with submucosal extension to the airway. Braz J Otorhinolaryngol 2020. 86 (1) p. .
Bleomycin sclerotherapy in patients with congenital and lymphatic malformation in the head and neck. Am J Otolaryngol 1995. 16 (4) p. .
Excellent Result with the Use of Single-Dose OK-432 in Cervical Macrocystic Lymphangioma. J Craniofac Surg 2016. 27 (7) p. .
Bleomycin sclerotherapy in congenital lymphatic and vascular malformations of head and neck. Int J Pediatr Otorhinolaryngol 2005. 69 (1) p. .
Treatment of cystic hygroma and lymphangioma with the use of bleomycin fat emulsion. Cancer 1987. 60 (4) p. .
Our experience with computed tomography-guided 98% sterile ethanol insertion and a review of the literature. J Pediatr Surg 2010. 45 (12) p. . (Sclerotherapy for cervical cystic lymphatic malformations in children)
Bleomycin Sclerotherapy in Lymphangiomas of Head and Neck: Prospective Study of 8 Cases. Indian J Otolaryngol Head Neck Surg 2018. 70 (1) p. .
Cystic lymphangioma: A differential diagnosis. J Oral Maxillofac Pathol 2015. 19 (3) p. .
A study of effects of pingyangmycin injection on treatment of lymphangiomas in oral, maxillofacial and cervical regions. Hua Xi Kou Qiang Yi Xue Za Zhi 2002. 20 (3) p. .
Isolated Lymphangiomatous Polyp Nasopharynx in an Adult First Case Report in English Literature. Indian J Otolaryngol Head Neck Surg 2014. 66 (4) p. .
Medical and sclerosing agents in the treatment of orbital lymphatic malformations: what's new?. Curr Opin Ophthalmol 2019. 30 (5) p. .
Efficacy of doxycycline and sodium tetradecyl sulfate sclerotherapy in pediatric head and neck lymphatic malformations. Int J Pediatr Otorhinolaryngol 2015. 79 (6) p. .
Evaluation of a New Method for the Treatment of Invasive, Diffuse, and Unexcisable Lymphangiomas of the Oral Cavity with Defocus CO2 Laser Beam: A 20-Year Follow-Up. Photomed Laser Surg 2016. 34 (2) p. .
Treatment of Cystic Hygroma in Children with Special Reference to OK-432 Therapy. Z Kinderchir 1987. 42 (5) p. .
Sclerotherapy of lymphangiomas of the head and neck. Sclerotherapy of Lymphangiomas. Head Neck 2011. 33 (11) p. .
Use of intralesional bleomycin as primary therapy in macrocystic lymphangiomas. Indian J Dermatol Venereol Leprol 2013. 79 (4) p. .
Intralesional Bleomycin in Lymphangioma: An Effective and Safe Non-Operative Modality of Treatment. J Cutan Aesthet Surg 2012. 5 (2) p. .
Lymphangioma: Is intralesional bleomycin sclerotherapy effective?. Biomed Imaging Interv J 2011. 7 (3) p. e18.